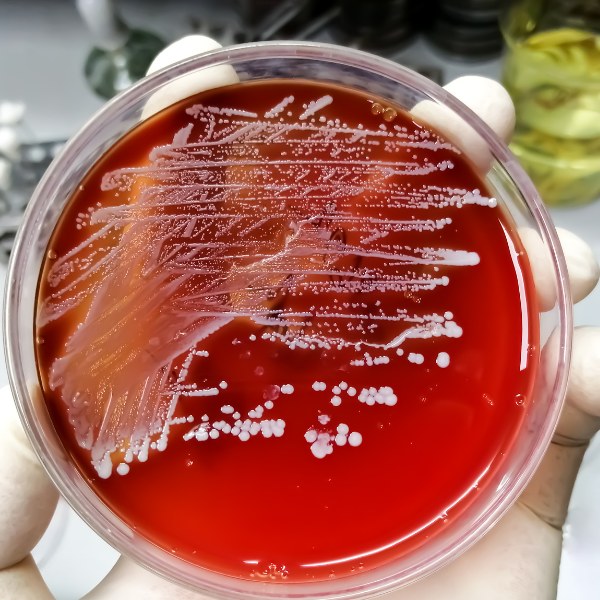
Staphylococcus aureus enterotoxin

Salmonella
Bacteria frequently associated with poultry, eggs, meat, and dairy.
- Common sources: Undercooked poultry/eggs, cross-contamination on boards/knives.
- Route: Ingestion of contaminated foods or surfaces (fecal–oral).
- Prevention: Cook poultry/eggs thoroughly, separate raw/ready foods, sanitize equipment.